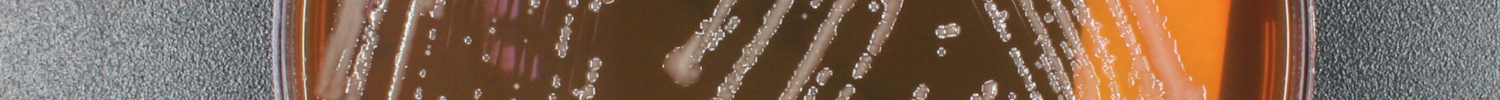

8 Module 8: Share Your Results
8.1 Overview
Week 15 is the capstone module. Students design or repeat an experiment, analyze the results, and connect the final experiment back to the semester’s genomic and phenotypic findings.
Figure Figure 8.1 provides a compact visual divider for the capstone week and surfaces the final remaining template image from the source document.
8.2 Purpose
- Identify a focused research question for a specific bacterial strain.
- Construct an experimental procedure.
- Determine how to gather accurate and representative data.
- Analyze results in the context of the experimental design.
8.3 Experiment Goals
List at least two specific goals for your final experiment.
- [Add goal here]
- [Add goal here]
8.4 Learning Outcomes
- List safety considerations for working with microbial isolates.
- Review techniques, concepts, and experiments from the course.
- Repeat experiments to improve consistency and reproducibility.
- Describe the purpose, methods, and results of the experiment your team designs.
- Interpret genomic data, including gene annotations and protein interaction predictions.
- Revise the draft for the individual and group projects.
- Explain how the experiment contributes to the overall research goal.
8.5 Skills and Knowledge
8.5.1 Skills
Specify the lab skills your final experiment develops.
- [Add skill here]
- [Add skill here]
8.5.2 Knowledge
Specify the concepts, tools, and analysis techniques that this final experiment reinforces.
- [Add knowledge area here]
- [Add knowledge area here]
8.6 Task
Review the background and procedure information you have written before coming to lab. Work with your group to carry out the experiment, document all changes, and analyze the resulting data.
8.7 Criteria for Success
Successful completion requires full participation in the designed experiment, careful documentation, and a complete ELN entry with results and reflection.
8.8 Background
Write a short paragraph describing your strain, the experiment your team will perform, the science behind it, and how the experiment supports your final research goal.
[Add background here]
8.9 Procedures
8.9.1 Lab Safety
8.9.1.1 Before Lab
- Wear lab coat, goggles, and gloves.
- Wipe the bench and pipettors with 70% ethanol.
8.9.1.2 During Lab
- Treat all tips as potential biohazards.
- Remove PPE when leaving the lab.
- Discard samples and disposables correctly.
- Minimize use of personal devices.
8.9.1.3 After Lab
- Wipe the station and any touched personal items with 70% ethanol.
- Dispose of gloves, plates, liquids, and glass in the correct locations.
- Return reusable materials, remove PPE, and wash your hands.
8.9.2 Methods
Write your methods so another group could reproduce the experiment, including setup, controls, measurements, and the data-analysis plan.
[Add methods here]
8.9.3 Protocol Notes
Record any changes, mistakes, or isolate-specific variables during the experiment.
8.10 Results
Summarize what happened and include figures, tables, or photos as needed.
[Add results here]
8.11 Result Analysis
Explain what the results mean and whether they matched expectations.
[Add analysis here]
8.12 Discussion Questions
- What did you learn from exploring your genome assembly and annotation with BV-BRC and SeqHub?
- Were you able to conduct and repeat your proposed experiment at least once? Why or why not?
- What findings did you obtain, and what are their implications?
- What experiment would you do next, and why?